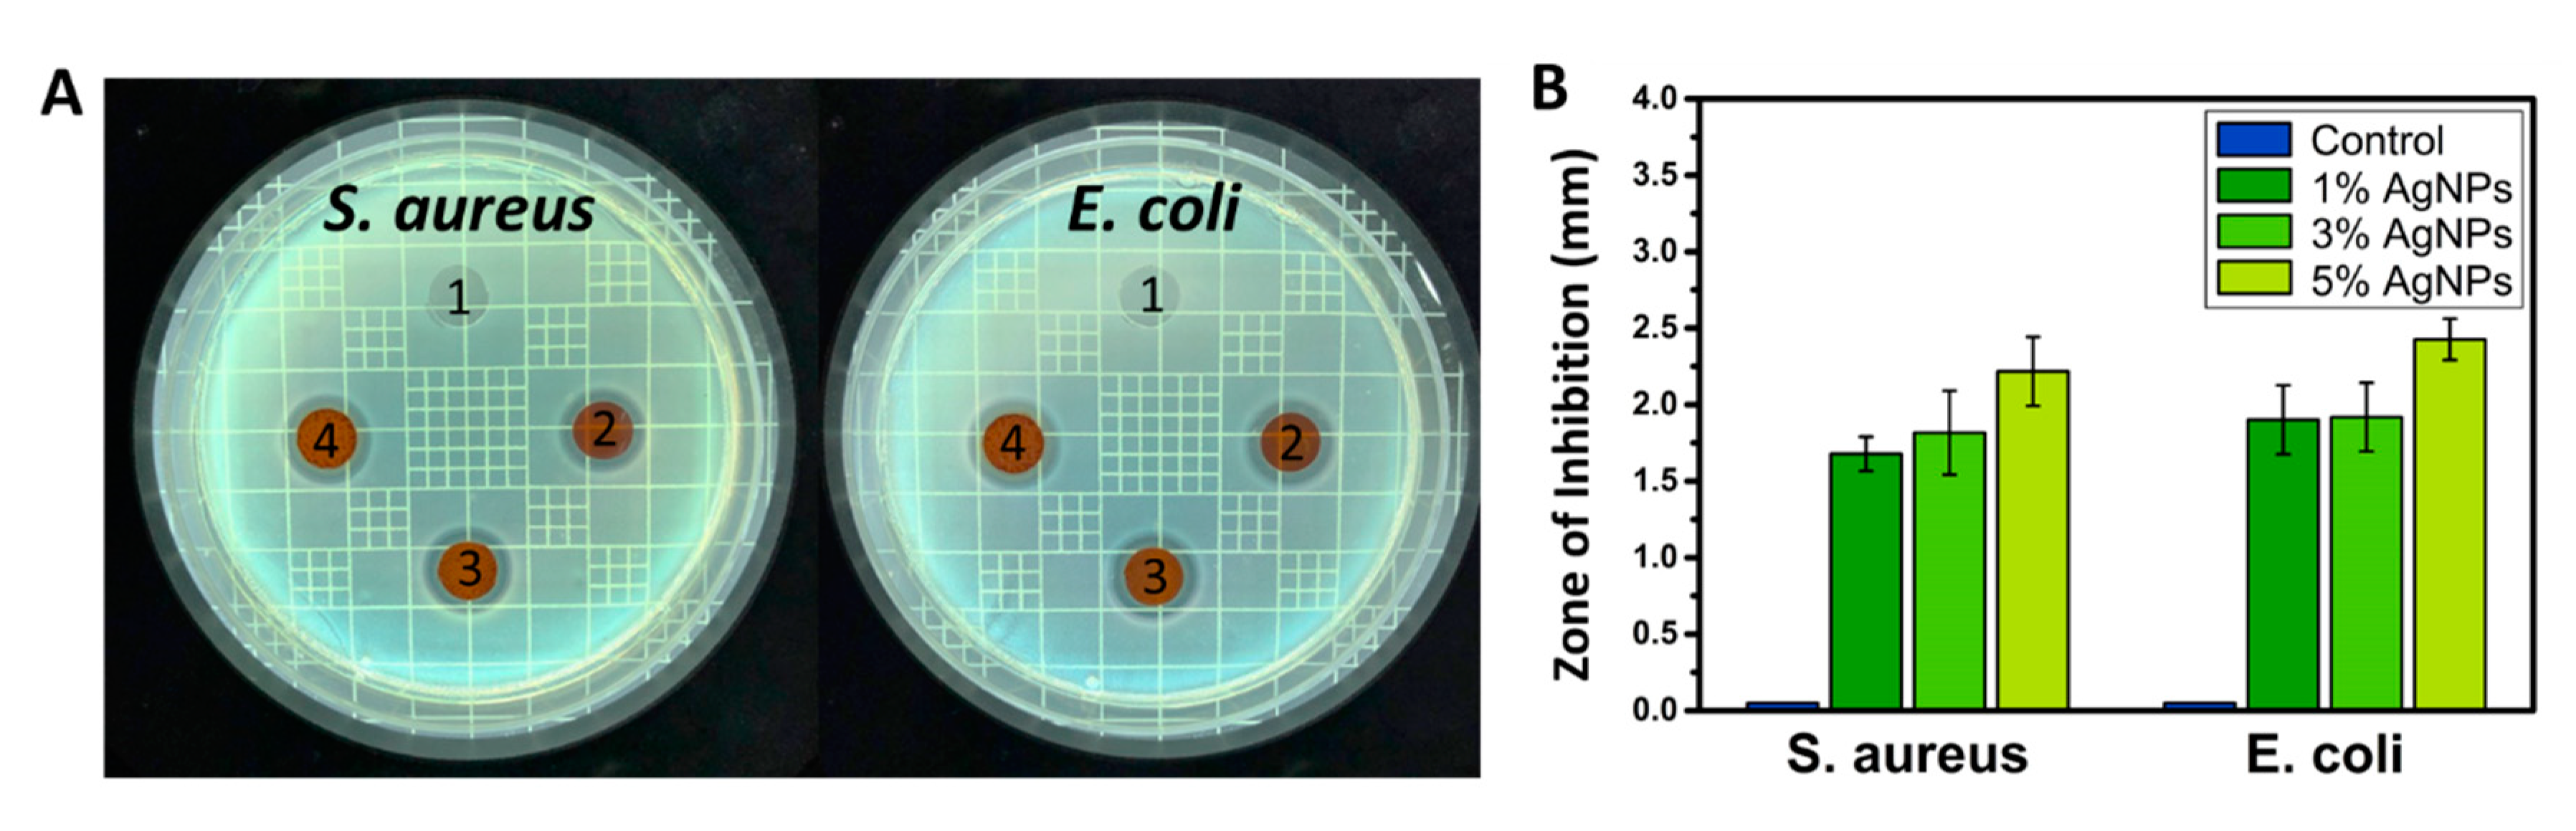
Nanomaterials 11 00486 g004 Nanomaterials 11 00486 g004

A Novel Design of Tri-Layer Membrane with Controlled Delivery of Paclitaxel and Anti-Biofilm Effect for Biliary Stent Applications
Abstract
1. Introduction
2. Experimental
2.1. Materials
2.2. Film Casting Method
2.3. Electrospinning Method
2.4. Characterizations
2.5. In Vitro Drug Release
2.6. Antibacterial Test
2.7. In Vitro Cytotoxicity Test
3. Results and Discussion
3.1. Morphological Characterization and Physicochemical Properties
3.2. In Vitro Drug Release Study
Mechanism of Drug Release
3.3. Antibacterial Test
3.4. In Vitro Cytotoxicity Test
4. Conclusions
Supplementary Materials
Author Contributions
Funding
Acknowledgments
Conflicts of Interest
References
- Virk, G.S.; Parsa, N.A.; Tejada, J.; Mansoor, M.S.; Hida, S. Successful stent-in-stent dilatation of the common bile duct through a duodenal prosthesis, a novel technique for malignant obstruction: A case report and review of literature. World J. Gastro Endos 2018, 10, 219–224. [Google Scholar] [CrossRef] [PubMed]
- Park, W.; Kim, K.Y.; Kang, J.M.; Ryu, D.S.; Kim, D.-H.; Song, H.-Y.; Kim, S.-H.; Lee, S.O.; Park, J.-H. Metallic stent mesh coated with silver nanoparticles suppresses stent-induced tissue hyperplasia and biliary sludge in the rabbit extrahepatic bile duct. Pharmaceutics 2020, 12, 563. [Google Scholar] [CrossRef] [PubMed]
- Shatzel, J.; Kim, J.; Sampath, K.; Syed, S.; Saad, J.; Hussain, Z.H.; Mody, K.; Pipas, J.M.; Gordon, S.; Gardner, T.; et al. Drug eluting biliary stents to decrease stent failure rates: A review of the literature. World J. Gastro Endos 2016, 8, 77–85. [Google Scholar] [CrossRef]
- Rezk, A.I.; Obiweluozor, F.O.; Choukrani, G.; Park, C.H.; Kim, C.S. Drug release and kinetic models of anticancer drug (BTZ) from a pH-responsive alginate polydopamine hydrogel: Towards cancer chemotherapy. Int. J. Biol. Macromol. 2019, 141, 388–400. [Google Scholar] [CrossRef]
- Wang, Z.; Liu, J.; Wu, K.; Shen, Y.; Mao, A.; Li, J.; Chen, Z.; Guo, S. Nitinol stents loaded with a high dose of antitumor 5-fluorouracil or paclitaxel: Esophageal tissue responses in a porcine model. Gastrointest Endosc. 2015, 82, 153–160.e151. [Google Scholar] [CrossRef]
- Lee, D.K.; Kim, H.S.; Kim, K.S.; Lee, W.J.; Kim, H.K.; Won, Y.H.; Byun, Y.R.; Kim, M.Y.; Baik, S.K.; Kwon, S.O. The effect on porcine bile duct of a metallic stent covered with a paclitaxel-incorporated membrane. Gastrointest Endosc. 2005, 61, 296–301. [Google Scholar] [CrossRef]
- Lee, S.S.; Shin, J.H.; Han, J.M.; Cho, C.H.; Kim, M.H.; Lee, S.K.; Kim, J.H.; Kim, K.R.; Shin, K.M.; Won, Y.H.; et al. Histologic influence of paclitaxel-eluting covered metallic stents in a canine biliary model. Gastrointest Endosc. 2009, 69, 1140–1147. [Google Scholar] [CrossRef] [PubMed]
- Kim, T.G.; Lee, H.; Jang, Y.; Park, T.G. Controlled Release of Paclitaxel from Heparinized Metal Stent Fabricated by Layer-by-Layer Assembly of Polylysine and Hyaluronic Acid-g-Poly(lactic-co-glycolic acid) Micelles Encapsulating Paclitaxel. Biomacromolecules 2009, 10, 1532–1539. [Google Scholar] [CrossRef] [PubMed]
- Jin, Z.; Wu, K.; Hou, J.; Yu, K.; Shen, Y.; Guo, S. A PTX/nitinol stent combination with temperature-responsive phase-change 1-hexadecanol for magnetocaloric drug delivery: Magnetocaloric drug release and esophagus tissue penetration. Biomaterials 2018, 153, 49–58. [Google Scholar] [CrossRef]
- Kim, S.Y.; Kim, M.; Kim, M.K.; Lee, H.; Lee, D.K.; Lee, D.H.; Yang, S.G. Paclitaxel-eluting nanofiber-covered self-expanding nonvascular stent for palliative chemotherapy of gastrointestinal cancer and its related stenosis. Biomed. Microdevices 2014, 16, 897–904. [Google Scholar] [CrossRef] [PubMed]
- Suk, K.T.; Kim, J.W.; Kim, H.S.; Baik, S.K.; Oh, S.J.; Lee, S.J.; Kim, H.G.; Lee, D.H.; Won, Y.H.; Lee, D.K. Human application of a metallic stent covered with a paclitaxel-incorporated membrane for malignant biliary obstruction: Multicenter pilot study. Gastrointest Endosc. 2007, 66, 798–803. [Google Scholar] [CrossRef]
- Yang, F.C.; Ren, Z.G.; Chai, Q.M.; Cui, G.Y.; Jiang, L.; Chen, H.J.; Feng, Z.Y.; Chen, X.H.; Ji, J.; Zhou, L.; et al. A novel biliary stent coated with silver nanoparticles prolongs the unobstructed period and survival via anti-bacterial activity. Sci. Rep. 2016, 6. [Google Scholar] [CrossRef]
- Galandi, D.; Schwarzer, G.; Bassler, D.; Allgaier, H.P. Ursodeoxycholic acid and/or antibiotics for prevention of biliary stent occlusion. Cochrane Database Syst. Rev. 2002. [Google Scholar] [CrossRef] [PubMed]
- Gwon, D.I.; Lee, S.S.; Kim, E.Y. Cefotaxime-eluting covered self-expandable stents in a canine biliary model: Scanning electron microscopic study of biofilm formation. Acta Radiol. 2012, 53, 1127–1132. [Google Scholar] [CrossRef]
- Donelli, G.; Guaglianone, E.; Di Rosa, R.; Fiocca, F.; Basoli, A. Plastic biliary stent occlusion: Factors involved and possible preventive approaches. Clin. Med. Res. 2007, 5, 53–60. [Google Scholar] [CrossRef]
- Gultepe, E.; Nagesha, D.; Sridhar, S.; Amiji, M. Nanoporous inorganic membranes or coatings for sustained drug delivery in implantable devices. Adv. Drug Deliv. Rev. 2010, 62, 305–315. [Google Scholar] [CrossRef]
- Francolini, I.; Donelli, G. Prevention and control of biofilm-based medical-device-related infections. Fems Immunol Med. Mic 2010, 59, 227–238. [Google Scholar] [CrossRef] [PubMed]
- Rigo, S.; Cai, C.; Gunkel-Grabole, G.; Maurizi, L.; Zhang, X.Y.; Xu, J.; Palivan, C.G. Nanoscience-Based Strategies to Engineer Antimicrobial Surfaces. Adv. Sci 2018, 5. [Google Scholar] [CrossRef]
- Rezk, A.I.; Ramachandra Kurup Sasikala, A.; Nejad, A.G.; Mousa, H.M.; Oh, Y.M.; Park, C.H.; Kim, C.S. Strategic design of a Mussel-inspired in situ reduced Ag/Au-Nanoparticle Coated Magnesium Alloy for enhanced viability, antibacterial property and decelerated corrosion rates for degradable implant Applications. Sci. Rep. 2019, 9, 117. [Google Scholar] [CrossRef] [PubMed]
- Ouadil, B.; Amadine, O.; Essamlali, Y.; Cherkaoui, O.; Zahouily, M. A new route for the preparation of hydrophobic and antibacterial textiles fabrics using Ag-loaded graphene nanocomposite. Colloids Surf. A Physicochem. Eng. Asp. 2019, 579, 123713. [Google Scholar] [CrossRef]
- Maharjan, B.; Joshi, M.K.; Tiwari, A.P.; Park, C.H.; Kim, C.S. In-situ synthesis of AgNPs in the natural/synthetic hybrid nanofibrous scaffolds: Fabrication, characterization and antimicrobial activities. J. Mech. Behav. Biomed. 2017, 65, 66–76. [Google Scholar] [CrossRef] [PubMed]
- Ramasamy, M.; Lee, J. Recent Nanotechnology Approaches for Prevention and Treatment of Biofilm-Associated Infections on Medical Devices. Biomed. Res. Int 2016, 2016. [Google Scholar] [CrossRef] [PubMed]
- Gao, L.; Wang, Y.; Li, Y.; Xu, M.; Sun, G.; Zou, T.; Wang, F.; Xu, S.; Da, J.; Wang, L. Biomimetic biodegradable Ag@ Au nanoparticle-embedded ureteral stent with a constantly renewable contact-killing antimicrobial surface and antibiofilm and extraction-free properties. Acta Biomater. 2020, 114, 117–132. [Google Scholar] [CrossRef] [PubMed]
- Deka, H.; Karak, N.; Kalita, R.D.; Buragohain, A.K. Bio-based thermostable, biodegradable and biocompatible hyperbranched polyurethane/Ag nanocomposites with antimicrobial activity. Polym. Degrad. Stab. 2010, 95, 1509–1517. [Google Scholar] [CrossRef]
- Rezk, A.I.; Bhattarai, D.P.; Park, J.; Park, C.H.; Kim, C.S. Polyaniline-coated titanium oxide nanoparticles and simvastatin-loaded poly(ε-caprolactone) composite nanofibers scaffold for bone tissue regeneration application. Colloids Surf. B Biointerfaces 2020, 192, 111007. [Google Scholar] [CrossRef]
- Nirmala, R.; Kalpana, D.; Navamathavan, R.; Lee, Y.S.; Kim, H.Y. Preparation and Characterizations of Silver Incorporated Polyurethane Composite Nanofibers via Electrospinning for Biomedical Applications. J. Nanosci. Nanotechno 2013, 13, 4686–4693. [Google Scholar] [CrossRef] [PubMed]
- Pastoriza-Santos, I.; Liz-Marzán, L.M. N, N-dimethylformamide as a reaction medium for metal nanoparticle synthesis. Adv. Funct. Mater. 2009, 19, 679–688. [Google Scholar] [CrossRef]
- Leung, J.W.; Liu, Y.L.; Desta, T.; Libby, E.; Inciardi, J.F.; Lam, K. Is there a synergistic effect between mixed bacterial infection in biofilm formation on biliary stents? Gastrointest Endosc. 1998, 48, 250–257. [Google Scholar] [CrossRef]
- Vaishnavi, C.; Samanta, J.; Kochhar, R. Characterization of biofilms in biliary stents and potential factors involved in occlusion. World J. Gastroentero 2018, 24, 112–123. [Google Scholar] [CrossRef]
- Rezk, A.I.; Kim, K.-S.; Kim, C.S. Poly(ε-Caprolactone)/Poly(Glycerol Sebacate) Composite Nanofibers Incorporating Hydroxyapatite Nanoparticles and Simvastatin for Bone Tissue Regeneration and Drug Delivery Applications. Polymers 2020, 12, 2667. [Google Scholar] [CrossRef]
- Rezk, A.I.; Lee, J.Y.; Son, B.C.; Park, C.H.; Kim, C.S. Bi-layered Nanofibers Membrane Loaded with Titanium Oxide and Tetracycline as Controlled Drug Delivery System for Wound Dressing Applications. Polymers 2019, 11, 1602. [Google Scholar] [CrossRef] [PubMed]
- Rezk, A.I.; Hwang, T.I.; Kim, J.Y.; Lee, J.Y.; Park, C.H.; Kim, C.S. Functional composite nanofibers loaded with β-TCP and SIM as a control drug delivery system. Mater. Lett. 2019, 240, 25–29. [Google Scholar] [CrossRef]
- Rezk, A.I.; Unnithan, A.R.; Park, C.H.; Kim, C.S. Rational design of bone extracellular matrix mimicking tri-layered composite nanofibers for bone tissue regeneration. Chem. Eng. J. 2018, 350, 812–823. [Google Scholar] [CrossRef]
- Sheikh, F.A.; Barakat, N.A.M.; Kanjwal, M.A.; Chaudhari, A.A.; Jung, I.H.; Lee, J.H.; Kim, H.Y. Electrospun Antimicrobial Polyurethane Nanofibers Containing Silver Nanoparticles for Biotechnological Applications. Macromol. Res. 2009, 17, 688–696. [Google Scholar] [CrossRef]
- Liao, C.Z.; Li, Y.C.; Tjong, S.C. Bactericidal and Cytotoxic Properties of Silver Nanoparticles. Int. J. Mol. Sci 2019, 20, 449. [Google Scholar] [CrossRef]

| Kinetics Models | Parameter | PU–PTX | PU–PTX–PCL |
|---|---|---|---|
| Zero order | R2 | 0.821 | 0.838 |
| First order | R2 | 0.914 | 0.896 |
| Korsemeyer–Peppas | R2 | 0.902 (n = 0.243) | 0.975 (n = 0.18) |
Publisher’s Note: MDPI stays neutral with regard to jurisdictional claims in published maps and institutional affiliations. |
© 2021 by the authors. Licensee MDPI, Basel, Switzerland. This article is an open access article distributed under the terms and conditions of the Creative Commons Attribution (CC BY) license (http://creativecommons.org/licenses/by/4.0/).
Share and Cite
Rezk, A.I.; Park, J.; Moon, J.Y.; Lee, S.; Park, C.H.; Kim, C.S. A Novel Design of Tri-Layer Membrane with Controlled Delivery of Paclitaxel and Anti-Biofilm Effect for Biliary Stent Applications. Nanomaterials 2021, 11, 486. https://doi.org/10.3390/nano11020486
Rezk AI, Park J, Moon JY, Lee S, Park CH, Kim CS. A Novel Design of Tri-Layer Membrane with Controlled Delivery of Paclitaxel and Anti-Biofilm Effect for Biliary Stent Applications. Nanomaterials. 2021; 11(2):486. https://doi.org/10.3390/nano11020486
Chicago/Turabian StyleRezk, Abdelrahman I., Jeesoo Park, Joon Yeon Moon, Sunny Lee, Chan Hee Park, and Cheol Sang Kim. 2021. "A Novel Design of Tri-Layer Membrane with Controlled Delivery of Paclitaxel and Anti-Biofilm Effect for Biliary Stent Applications" Nanomaterials 11, no. 2: 486. https://doi.org/10.3390/nano11020486
APA StyleRezk, A. I., Park, J., Moon, J. Y., Lee, S., Park, C. H., & Kim, C. S. (2021). A Novel Design of Tri-Layer Membrane with Controlled Delivery of Paclitaxel and Anti-Biofilm Effect for Biliary Stent Applications. Nanomaterials, 11(2), 486. https://doi.org/10.3390/nano11020486
